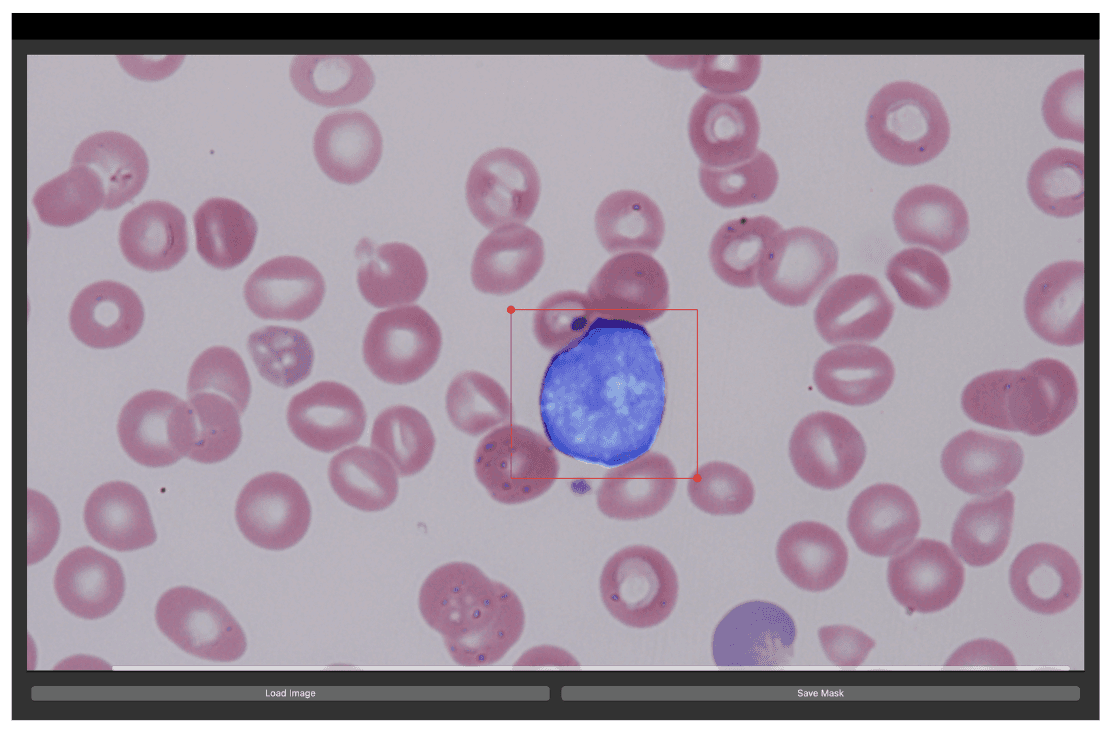
Verve Dent - Mobile

Leukemia is a diverse group of cancers originating in the blood-forming tissues, such as the bone marrow, and it presents significant diagnostic challenges due to its varied subtypes and overlapping clinical symptoms. Subtypes such as Acute Lymphoblastic Leukemia (ALL), Acute Myeloid Leukemia (AML), Chronic Lymphocytic Leukemia (CLL), and Chronic Myeloid Leukemia (CML) differ significantly in their progression and response to treatments. Accurate classification of these subtypes is vital for effective patient management and personalized treatment plans.
This project proposes a transformative approach that combines cell-level segmentation with multiple-instance learning (MIL) to address these diagnostic challenges. By using segmentation masks to identify individual cells, the MIL framework processes each segmented cell as a unique instance, improving the model’s ability to detect subtle morphological differences across leukemia subtypes. This unified approach ensures cohesive diagnostic outputs, which help overcome the inconsistencies seen in conventional methods that treat each sample separately.
AI Implementation:
The AI implementation in this project focuses on the integration of advanced segmentation models and multiple-instance learning to classify leukemia subtypes with higher precision. The implementation is broken down into several key steps:
Cell Segmentation: The model uses DeepLabV3 with a ResNet50 backbone for cell segmentation, which allows it to accurately delineate individual white blood cells. The segmentation model is trained using cross-entropy loss and optimized through atrous convolutions that capture multi-scale information.
Multiple Instance Learning (MIL): After the images are segmented, the model treats each cell (or patch) as an instance within a "bag" that represents the entire sample. By using attention mechanisms in the MIL framework, the model weighs each instance based on its contribution to the overall classification, improving the detection of subtle morphological differences across subtypes.
Radiomics Feature Extraction: The model extracts radiomic features from segmented regions of interest (ROIs) within the images. These features capture the texture, shape, and intensity of the white blood cells, providing crucial data for more nuanced subtype classification.
Classification Model: A comparison of different architectures such as ResNet50, DenseNet121, and Vision Transformers (ViT) is conducted. The original images and segmentation masks are used as input to understand the impact of cell segmentation on the model's ability to classify leukemia subtypes.
Datasets:
The dataset used in this project is a private collection from SSMC, consisting of 4,289 blood films from 99 patients. Each slide contains four films, and the dataset is stratified into five diagnostic categories:
Normal (Healthy Control)
Acute Myeloid Leukemia (AML)
Chronic Myeloid Leukemia (CML)
Acute Lymphatic Leukemia (ALL)
Chronic Lymphatic Leukemia (CLL)
This diverse dataset forms the foundation for training the model, allowing it to learn from subtle morphological variations that are indicative of each condition(AI702_Project_Report).
Methodology:
The project follows a structured pipeline, divided into the following key phases:
Data Pre-processing:
Images are normalized using stain normalization to address inconsistencies across samples. This step is crucial to ensure that the variations in staining procedures from different laboratories do not affect the model's performance.
Each image is resized to 448x448 pixels for uniformity in input during model training.
Segmentation Mask Generation:
The MedSAM tool is used for manual segmentation, and the results are used to train DeepLabV3. This ensures that each white blood cell is precisely segmented.
The post-processing phase converts the generated masks into binary formats for further use in semantic segmentation tasks.
Classification:
After segmenting the cells, a classification model based on ResNet50, DenseNet121, and Vision Transformer (ViT) architectures is used to identify leukemia subtypes. Both original images and overlayed segmentation masks are used for the classification task to evaluate the impact of segmentation.
Multiple Instance Learning (MIL):
The MIL framework treats each cell patch as an individual instance and uses an attention-based mechanism to aggregate the most informative instances. This approach helps in distinguishing leukemia subtypes with greater accuracy.
Multimodal Experiment:
A multimodal approach that integrates both image and radiomic data is explored, which aims to extract richer features by combining cell morphology and internal texture data for a comprehensive classification task.
Results:
The project provides extensive quantitative and qualitative results, demonstrating the effectiveness of different models across classification tasks:
Quantitative Results:
The Vision Transformer (ViT) achieved the highest accuracy of 89.94% with an F1-score of 83.67% when classifying original images.
The Multiple Instance Learning (MIL) approach using patches resulted in the best performance, achieving an accuracy of 90.07% and an F1-score of 89.74%. This method clearly outperforms traditional models, demonstrating the benefits of using instance-based analysis.
Qualitative Results:
Qualitative analysis reveals that the segmentation masks generated by DeepLabV3 are consistent with the white blood cell locations, confirming that the segmentation approach accurately identifies regions of interest for leukemia subtype classification.
Conclusion:
This project successfully integrates cell-level segmentation and multiple-instance learning to enhance the classification of leukemia subtypes. By combining segmentation with radiomic feature extraction and instance-based analysis, the model demonstrates improved accuracy and precision in diagnosing leukemia. Future work will involve expanding the dataset and refining the classification models to further enhance the system’s adaptability and robustness in clinical settings.